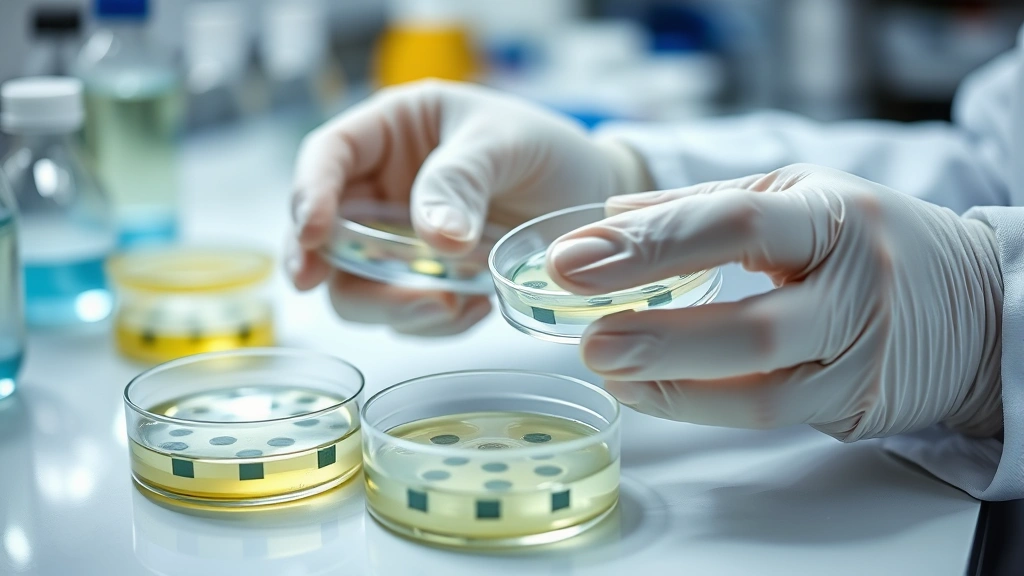
Close-up of scientist's hands carefully handling petri dishes with bacterial cultures, sterile technique demonstration, laboratory bench with growth media and instruments, professional scientific environment

Master Bacterial Growth Stages: Microbiologist Insights
Understanding the phases of bacterial growth is fundamental to microbiology, food safety, medicine, and biotechnology. Just as human development follows predictable stages, bacterial populations move through distinct phases that reveal critical insights into how microorganisms thrive, adapt, and respond to environmental pressures. This comprehensive guide explores each growth phase with scientific precision and practical applications that professionals and students need to master.
Bacterial growth follows a fascinating biological pattern that mirrors principles found in personal growth cycles—periods of rapid expansion, plateaus, and decline. By examining these microbial growth stages, we unlock knowledge applicable to antibiotic resistance, fermentation processes, contamination control, and biotechnology innovation. Whether you’re a microbiology student, healthcare professional, or researcher, mastering these phases transforms your understanding of microbial behavior.
The Lag Phase: Adaptation and Preparation
When bacteria are introduced to a new environment, they don’t immediately begin dividing rapidly. Instead, they enter the lag phase, a critical adaptation period that can last from minutes to hours depending on conditions. During this phase, bacterial cells are essentially “waking up” and preparing for growth.
In the lag phase, bacteria synthesize essential enzymes, proteins, and nucleic acids necessary for survival and reproduction. Cell size increases, metabolic activity intensifies, and the organisms adjust to their new surroundings. This resembles the growth mindset principle—organisms must mentally and physically prepare before rapid advancement occurs.
Several factors influence lag phase duration. Temperature changes, nutrient availability, pH adjustments, and osmotic stress all impact how quickly bacteria acclimate. Cells that recently divided experience shorter lag phases compared to stationary-phase cells being transferred to fresh media. Understanding this phase is crucial for clinical diagnostics, where delayed growth can affect infection identification timelines.
The lag phase demonstrates bacterial resilience and adaptability. Microorganisms possess remarkable genetic flexibility, activating dormant genes and metabolic pathways to match environmental demands. This adaptive capacity explains why some pathogens develop antibiotic resistance—they’re utilizing lag-phase time to produce resistance enzymes and modify cellular structures.
The Log Phase: Exponential Growth
Following successful adaptation, bacteria enter the log phase (logarithmic or exponential phase), where growth accelerates dramatically. During this phase, bacterial cells divide at their maximum rate, typically doubling every 20-30 minutes under optimal laboratory conditions, though this varies significantly by species.
In the log phase, cells are metabolically active, synthesizing DNA, RNA, and proteins at peak rates. The population doubles exponentially—one cell becomes two, two become four, four become eight, and so forth. This mathematical progression explains why bacterial infections can become serious rapidly if untreated. A single pathogenic bacterium can theoretically produce millions of descendants within hours.
The log phase represents the optimal window for observing bacterial physiology because cells are in their most uniform metabolic state. All cells are actively dividing, nutrient utilization is consistent, and waste production is predictable. This makes the log phase ideal for research, antibiotic susceptibility testing, and vaccine development studies.
Several conditions maintain log-phase growth. Abundant nutrients, optimal temperature, appropriate pH, adequate oxygen (for aerobic organisms), and minimal toxic waste accumulation all sustain exponential growth. When any of these factors becomes limiting, bacteria cannot maintain log-phase rates and transition toward stationary phase. This principle applies to personal growth and development—optimal conditions enable sustained progress, while resource limitations force adaptation.
Understanding log-phase dynamics is essential for industrial applications. Pharmaceutical companies exploit log-phase growth to maximize antibiotic or vaccine production. Food manufacturers monitor for log-phase bacterial growth to prevent spoilage and ensure safety. Healthcare facilities use log-phase knowledge to predict infection progression and guide treatment decisions.
The Stationary Phase: Equilibrium
As nutrients deplete and waste products accumulate, bacterial growth rate slows and eventually plateaus. The population enters the stationary phase, where the number of new cells produced equals the number dying. The population size remains relatively constant, though individual cells continue metabolic activity.
The stationary phase typically lasts longer than log phase and represents a survival strategy. Bacteria reduce metabolic rates, accumulate storage compounds, and produce protective mechanisms like spore formation or biofilm development. Cellular composition shifts—cells become smaller, produce less RNA, and synthesize stress-response proteins.
During stationary phase, bacteria demonstrate remarkable behavioral changes. Some species produce secondary metabolites with antimicrobial properties, competing for remaining resources. Others form protective biofilms—organized communities encased in polysaccharide matrices that provide structural support and chemical defense. These adaptations show how journal prompts for self-growth encourage reflection—bacteria essentially assess their situation and adjust strategies accordingly.
The stationary phase carries significant clinical implications. Stationary-phase bacteria often display increased antibiotic resistance compared to log-phase cells. This explains why persistent infections are difficult to treat—pathogenic bacteria shift into survival mode, reducing antibiotic susceptibility. Understanding this phenomenon helps clinicians optimize treatment timing and dosing strategies.
Stationary phase also represents an opportunity for genetic exchange. Bacteria accumulate mutations, share DNA through conjugation or transformation, and generate genetic diversity. This genetic flexibility enables rapid adaptation to environmental challenges, including immune system attacks and antimicrobial exposure.
The Death Phase: Decline and Survival
If stationary conditions persist without nutrient replenishment, bacteria eventually enter the death phase (decline phase), where mortality exceeds reproduction. Cell numbers decrease as organisms exhaust remaining resources and toxic waste accumulates to lethal concentrations.
Death phase progression varies dramatically by species and conditions. Some bacteria die rapidly—hours to days—while others persist for weeks or months through sporulation or entering viable-but-nonculturable (VBNC) states. VBNC bacteria remain alive but cannot be cultured using standard laboratory methods, representing a survival strategy that complicates detection and infection control.
Interestingly, death-phase cells sometimes exhibit surprising resilience. Certain bacteria produce antibiotics or toxins that kill competitors, allowing resource salvage from deceased neighbors. This “bacterial cannibalism” demonstrates sophisticated chemical warfare and scavenging behavior. Some species activate stationary-phase genes that enhance survival, essentially creating a second defensive layer.
Understanding death-phase dynamics informs disinfection and sterilization protocols. Medical facilities must recognize that dying bacterial populations may behave unpredictably—some cells become more resistant to antimicrobials as they activate survival genes. This explains why consistent, adequate disinfectant exposure is critical; incomplete treatment may select for resistant survivors.
The death phase also connects to best books for self-growth concepts—accepting decline and endings represents important growth phases. Just as bacterial populations eventually decline, individuals experience seasons of reduced productivity or progress. Recognizing these cycles as natural rather than failures enables healthier perspective and strategic planning.

Factors Affecting Bacterial Growth
Multiple environmental and nutritional factors influence which growth phase bacteria occupy and how rapidly they progress through each stage.
Temperature
Temperature dramatically affects bacterial metabolism and growth rates. Each bacterial species has an optimal growth temperature, typically ranging from 15°C (psychrophiles) to 80°C+ (thermophiles). Most pathogenic bacteria grow optimally at human body temperature (37°C). Temperature changes slow or accelerate enzyme activity, directly impacting growth phase progression.
Nutrient Availability
Carbon sources (glucose, acetate), nitrogen sources (amino acids, ammonia), phosphorus, sulfur, and trace elements fuel bacterial growth. Nutrient limitation forces transition from log to stationary phase. This principle guides personal growth thesaurus terminology—organisms require proper “fuel” for advancement, whether biological or psychological.
Oxygen Availability
Aerobic bacteria require oxygen for efficient energy production through cellular respiration. Anaerobic bacteria thrive without oxygen or even die in its presence. Facultative anaerobes adjust their metabolism based on oxygen presence. Oxygen levels determine which bacterial species dominate environments and how rapidly they grow.
pH Levels
Most bacteria prefer neutral pH (6.5-7.5), though some thrive in acidic or alkaline conditions. pH affects enzyme function, membrane integrity, and nutrient availability. Extreme pH values arrest growth or trigger death phase, making pH control essential in food preservation and pharmaceutical manufacturing.
Osmotic Pressure
Salt concentration and water availability influence bacterial cell turgor and metabolism. Halophilic bacteria tolerate high salt; osmotic stress can trigger stationary phase or death in salt-sensitive species. This principle explains why salt preserves food—it creates osmotic conditions incompatible with pathogenic bacteria growth.
Practical Applications in Science and Industry
Clinical Microbiology and Diagnostics
Understanding growth phases enables faster pathogen identification. Clinical laboratories exploit log-phase growth characteristics to quickly culture suspected pathogens and perform susceptibility testing. Recognizing that certain bacteria remain viable but nonculturable after treatment prevents false-negative results and ensures appropriate patient care.
Food Safety and Preservation
Food manufacturers apply growth-phase knowledge to prevent spoilage and pathogenic contamination. By controlling temperature, pH, and oxygen levels, companies keep bacteria in lag or slow-growth phases. Fermentation industries deliberately maintain log-phase conditions to maximize beneficial bacterial production while preventing contamination.
Pharmaceutical and Biotechnology Production
Antibiotic and vaccine manufacturers carefully control growth conditions to maximize log-phase bacterial activity. Bioreactors maintain optimal temperature, nutrient levels, pH, and aeration to sustain exponential growth. Understanding growth-phase transitions helps optimize harvest timing—collecting cells at peak metabolic activity maximizes product yield.
Wastewater Treatment
Treatment plants exploit bacterial growth phases to remove contaminants. Activated sludge systems maintain conditions favoring log-phase growth of beneficial decomposer bacteria that break down organic matter. Understanding growth dynamics prevents system crashes caused by sudden environmental changes.
Environmental Monitoring
Microbiologists assess water quality and environmental contamination by analyzing bacterial growth patterns. Rapid growth indicates abundant nutrients and potential pollution; slow or absent growth suggests clean conditions. Growth-phase analysis reveals which bacteria dominate specific environments and how conditions might be affecting microbial communities.
Measuring and Monitoring Growth
Scientists employ multiple techniques to track bacterial growth and identify which phase cultures occupy.
Viable Plate Counting
Colony-forming unit (CFU) counting remains the gold standard for viable cell enumeration. Serial dilutions of bacterial cultures are plated on nutrient media, grown overnight, and colonies are counted. This method identifies viable, culturable cells and produces quantitative growth curves showing all four phases.
Optical Density Measurement
Spectrophotometry measures light absorbance by bacterial cultures at 600 nanometers (OD600). As bacterial density increases, light absorbance increases proportionally. This rapid, non-destructive method monitors growth in real-time but cannot distinguish viable from dead cells.
Direct Microscopic Counting
Hemocytometers or flow cytometry count total cells regardless of viability. This method detects both living and dead bacteria, useful for detecting viable-but-nonculturable cells that viable plate counting misses.
Metabolic Assays
Enzyme-based assays measure bacterial metabolic activity by detecting substrate consumption or product formation. These methods correlate with growth phase and reveal metabolic state without requiring growth on media.
Molecular Methods
DNA quantification (qPCR) and RNA analysis measure genetic material accumulation, indicating growth and metabolic activity. These modern techniques provide precise growth data and can identify specific bacterial species simultaneously.
FAQ
How long does each bacterial growth phase typically last?
Duration varies dramatically by species and conditions. Lag phase typically lasts 30 minutes to several hours. Log phase can persist for hours to days with continuous nutrient replenishment. Stationary phase lasts days to weeks. Death phase varies from hours to months depending on species and environmental conditions.
Why do bacteria in stationary phase become more antibiotic-resistant?
Stationary-phase bacteria activate stress-response genes that produce protective enzymes, modify cell walls, and reduce metabolic rates. These changes decrease antibiotic penetration and reduce targets for antibiotic action. Additionally, stationary-phase cells have accumulated protective compounds like spores or biofilm matrices.
Can bacteria skip growth phases?
No, all bacteria must transition through lag, log, stationary, and eventually death phases under closed-system conditions. However, continuous nutrient replenishment (as in flowing water systems) can maintain log-phase growth indefinitely, bypassing stationary and death phases.
How do viable-but-nonculturable bacteria affect infection control?
VBNC bacteria remain alive and potentially infectious but cannot be cultured on standard media, making them invisible to traditional detection methods. This complicates sterilization verification and infection control assessments. Modern molecular methods can detect VBNC bacteria that viable plate counting misses.
Why is understanding growth phases important for antibiotic therapy?
Many antibiotics work most effectively against log-phase bacteria when cells are actively synthesizing DNA, RNA, and proteins. Stationary-phase bacteria show reduced antibiotic susceptibility. Optimal treatment timing considers bacterial growth phase—treating early infections when bacteria are in log phase improves outcomes.
How do environmental conditions affect growth-phase transitions?
Temperature, pH, nutrient availability, oxygen levels, and osmotic pressure all influence growth rates and phase transitions. Suboptimal conditions accelerate transitions to stationary and death phases. Understanding condition effects enables manipulation of bacterial growth for industrial, clinical, or research purposes.